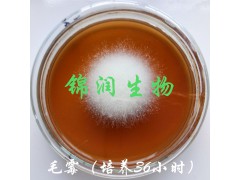
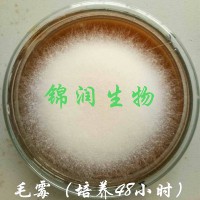

一、概述
毛霉是一种丝状真菌,具有发达的白色菌丝。它的菌丝可分为直立菌丝和匍匐菌丝。繁殖方式为孢子生殖,新陈代谢类型为异养需氧型。毛霉菌菌种可在10~35℃左右生长,最适温度在20~25℃。本菌种菌丝洁白浓密似兔毛状,可在豆腐上旺盛生长,做出的腐乳风味优良。
二、产品优势
1、菌种优良,不产生其他任何毒素,生长繁殖快,且抗杂菌力强;
2、生长的温度范围大,不受季节的限制;
3、有蛋白酶、脂肪酶、肽酶等丰富的酶系,制成的产品风味独特,口感醇厚。
三、发酵步骤
1、促长和控长:即先创造适宜的条件让毛霉生长,当发酵到一定程度时,再加盐抑制毛霉的生长。加卤汤的作用有两个方面,一是进一步控制毛霉和其他杂菌的生长,避免腐乳腐败,延长腐乳的贮藏时间;二是改变腐乳的口感和风味。
2、后发酵:前期发酵完成后,腐乳还有一定的生味,此时并不适合直接食用,需要一个月以上的后期发酵才能达到最佳效果。后期发酵利用的是被杀死后的毛霉裂解释放出来的各种分解酶的作用,经过后期发酵,腐乳就能直接食用了。
四、在腐乳上的使用说明
1、将硬实一点的新鲜豆腐切成3厘米见方的小方块,蒸熟,待降温至30度以下。
2、将毛霉菌粉加入大约20倍重量的凉开水,充分搅拌使孢子释放在水中,然后用细布过滤,将过滤好的毛霉菌液,均匀的喷洒在豆腐表面,要求豆腐的五个面必须喷洒均匀,或者取豆腐直接在菌液中沾一下,然后均匀放在平盘上,每块豆腐之间要留有一定的空隙,以防粘连。
3、在15℃~25℃培养条件下(培养温度越低越不易污染杂菌),2~3天即长出白色或者灰白色长绒毛,这是毛霉菌丝。此时即可进行腌制。
4、取精盐(一般豆腐与食盐的质量比例为6:1)、五香粉、黄酒、辣椒、糖等(依个人口味喜好而定,喜欢清淡的可以只加盐水)搅拌均匀,将发酵的豆腐放入瓶内或者坛内腌制,必须将坛口或者瓶口封严,20天左右即可食用,时间稍长,味道更醇厚。
五、影响腐乳发酵的一些关键因素
1、豆腐的品质。目前从市场上购买的豆腐有两种类型,一类是由石膏形成的,另一类是由卤水形成的。前者豆腐细嫩,口感好,但含水量多,后者含水量相对较低,含水量较少的比较适宜用于制作腐乳。如果控水容易,也可选择前者。
2、杂菌的污染。让毛霉形成种群优势,除了创造毛霉生长的环境条件外,还要避免豆腐受到其他杂菌的污染,一旦杂菌如其他细菌和真菌大量繁殖,毛霉就不能形成种群优势,豆腐就会受到污染,制作就会失败。
3、温度和湿度。毛霉生长需要的适宜温度为20~25℃。夏季制作腐乳时,因气温高,细菌和其他真菌容易生长,制作的腐乳容易腐败;冬季制作腐乳时可用棉布保温,北方地区房间有暖气,可放在靠近暖气管的地方。湿度大的情况下毛霉容易生长繁殖,干燥的环境容易导致毛霉老化,变成黄色或褐色使发酵程度不够。如果气温干燥,可用保鲜膜或塑料袋封口保湿。
4、腌制时的加盐量。食盐不仅可以杀死毛霉,抑制其生长,而且是腐乳的第一调味品。盐量和佐料的多少将直接影响腐乳的品质,盐加多了,腐乳发酵程度不够;盐加少了,又容易造成细菌和其他真菌生长,腐乳因变质而无法食用。加盐量还与个人的口味有关,因此需要在实践中不断摸索,一般豆腐与食盐的质量比例为6:1。
六、接种量:2‰(如50kg豆腐用毛霉菌粉100克)。
七、保质期:8个月
八、保存方法:25℃以下,阴凉干燥处密封保存。